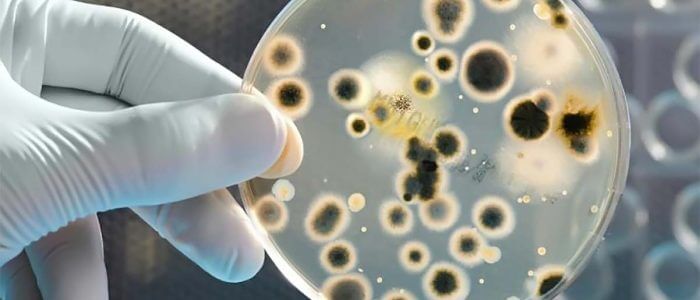

Вугрі на обличчі доставляють безліч незручностей, особливо якщо спровоковані бактеріальною інфекцією. Крім запалення з набряком і почервонінням шкірного покриву, з’являється свербіж, біль і печіння. Такі недоліки можуть виникнути в будь-якому віці через закупорку пір на тлі неправильного догляду за шкірою. Варто визначити тип бактеріального агента і приступити до лікування. У цьому допоможе дерматолог.
Причини виникнення
Вугровий висип може з’явитися з-за бактерій, які живуть на шкірному покриві людини, точніше в порах. При сприятливих умовах ці мікроорганізми починають активно розвиватися, виробляти жирні кислоти з короткими ланцюгами, які впливають на процеси відділення кератиноцитів (ороговілих клітин). Організм, у свою чергу, запускає місцевий імунітет для захисту з виділенням цитокінів — білків, що провокують шкірні запалення.
Цікаво, що бактерії є лише другорядною причиною прищів або наслідком. Найчастіше провокаторами виступають зміни в організмі, що знижують захисні властивості шкірного сала, чому секрет стає ідеальним для розвитку патогенів.
Які мікроорганізми викликають вугри?

Велика кількість вугрової висипки викликана бактерією — Propionibacterium acnes. Живе в фолікулах волосся. Вчені виділяють два види цієї бактерії. Перший — не несе різних захворювань, живе на шкірі людини весь час на відміну від інших мікроорганізмів. Другий — є збудником появи вугрів на шкірному покриві. Вони не потребують в постійному доступі кисню, тому активно розмножуються в придатних умовах, таких як закупорка сальних проток. Разом з жиром і відмерлими клітинами епідермісу провокують появу вугрів і утворення нових прищів.
Лікування вугрової висипки
Для зменшення висипань слід застосовувати:
- Антибіотики. Призначаються виключно лікарем. Розрізняють місцеві («Метрогіл», «Клензит», еритроміцин і тетрациклін у вигляді мазей, бовтанки) і системні в формі таблеток, якщо причина криється усередині.
- Азелаїнова кислота. Здатна зменшити появу вугрів і прищів. Має протизапальну і антикомедогенным дією. Застосовується в гелі, креми, спреї, лосьйони, тоніках, сироватках.
- Саліцилова кислота. Зменшує почервоніння, підсушує шкіру.
- Комплекси з ретиноїдами і антибіотиками — «Клензит-З», «Эффезел», «Изотрексин». Препарати пригнічують популяції бактерій Prop. acnes, регулюють секрецію і склад сального секрету.
На думку спеціалістів, лікування одними антибіотиками малоефективно (до 45%), а от при застосуванні комбінованої схеми результат піднімається до 80%. Салонні чищення та косметику на період лікування краще не застосовувати, тому що бактерії викликають сильне запалення, а подібні процедури здатні спровокувати гнійний процес. У якості гігієнічних процедур краще віддати перевагу частим умываниям теплою водою і раз в день — водою з антисептичним милом або м’яким гелем.
Важливо підібрати правильний догляд за шкірою, щоб знизити появи вугрів від бактерій. Для цього краще проконсультуватися з косметологом.
Якщо вугри не сходять, краще звернутися до лікаря-дерматолога або косметолога. Не варто видавлювати прищі, особливо це стосується області носогубного трикутника, так може з’явитися ще більше висипань і збільшиться ризик занесення інфекції в кров. Важливо дотримуватися інструкцій і порад медичних працівників для отримання належного результату і повного вилікування хвороби.